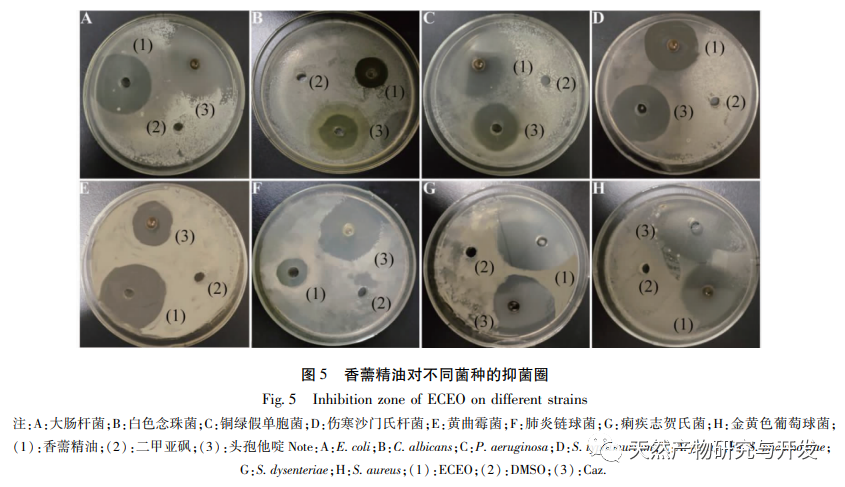

Untersuchung der Zusammensetzung und der antioxidativen und antibakteriellen Aktivitäten des ätherischen Öls von Elsholtzia
Die Antibiotikaresistenz ist im 21. Jahrhundert zu einer großen Herausforderung geworden. Die American Infectious Diseases Association hat sechs Arten von arzneimittelresistenten Bakterien, darunter Enterococcus faecalis, Staphylococcus aureus, Klebsiella pneumoniae, Acinetobacter baumannii, Pseudomonas aeruginosa und Escherichia coli, als äußerst gefährlich eingestuft. Für die Patienten besteht nach einer Infektion ein hohes Risiko für Behinderungen und Tod, und es gibt derzeit keinen Behandlungsplan. Bei der Aromatherapie handelt es sich um eine Art von Medikamenten, die die Wirkung haben, Krankheitserreger an der Oberfläche zu vertreiben und die Symptome an der Oberfläche zu lindern, und die häufig bei Infektionen der Atemwege eingesetzt werden. Ätherische Öle, die aus aromatischen Drogen extrahiert werden, können eine starke antibakterielle Wirkung entfalten, indem sie Zellwände und Bakterienmembranen auflösen, so dass bakterielle Inhalte austreten. Darüber hinaus haben Forscher herausgefunden, dass ätherische Pflanzenöle die Antibiotikaresistenz verringern können und wirksame Substanzen zur Abtötung arzneimittelresistenter Stämme sind.
Elsholtzia ciliata (Thunb.) Hyland Es gehört zur Kategorie der aromatischen, oberflächenentlastenden Drogen und ist eine krautige Pflanze aus der Familie der Lamiaceae, die zur Gattung Elsholtzia gehört. Sie kann als ganzes Kraut zu medizinischen Zwecken verwendet werden, hat einen scharfen Geschmack und eine leicht warme Natur. Sie wirkt schweißtreibend, feuchtigkeitsentziehend, harntreibend und abschwellend. Die moderne Forschung hat gezeigt, dass das ätherische Öl von Elsholtzia ciliata (ECEO) Bestandteile wie Phenylpropanoide, Flavonoide, Phenole und Terpene enthält und verschiedene biologische Aktivitäten wie antibakterielle, grippehemmende, insektenhemmende und antioxidative Eigenschaften aufweist. Frühere Studien haben gezeigt, dass ECEO eine starke antibakterielle Wirkung auf Escherichia coli und Bacillus subtilis hat. Darüber hinaus kann der Elsholtzia-Extrakt den oxidativen Stress und die Entzündungswerte in J774A. 1-Zellen reduzieren. Allerdings gibt es derzeit nur wenige Literaturberichte über die Prävention und Verzögerung von Antibiotikaresistenzen durch ECEO. Daher werden in dieser Studie die chemische Zusammensetzung, die antioxidative Kapazität und die antibakterielle Aktivität von ECEO untersucht, um eine Referenz für die umfassende Entwicklung des ätherischen Öls von Elsholtzia zu erhalten.

Durch GC-MS-Analyse wurden sieben Verbindungen im ätherischen Öl von Elsholtzia identifiziert, wobei die Hauptkomponenten Thymol (79,17%) und 4-Isopropyl-3-methylphenol (12,35%) waren. Die FTIR-Analyse ergab, dass das ätherische Öl von Elsholtzia funktionelle Gruppen wie Hydroxyl und Doppelbindungen enthält. Yang et al. wiesen auch darauf hin, dass der Hauptbestandteil des ätherischen Öls von Elsholtzia Thymol ist. Die antioxidativen Ergebnisse deuten darauf hin, dass das ätherische Öl von Elsholtzia ein starkes DPPH-Fängervermögen und ein β-Karotin-Bleichvermögen besitzt, was mit den phenolischen Substanzen im ätherischen Öl von Elsholtzia zusammenhängen könnte. Die Forschung hat gezeigt, dass der Benzolring von Thymol, dem Hauptbestandteil des ätherischen Öls von Elsholtzia, wasserstoffspendende Hydroxylgruppen enthält, die die Fähigkeit haben, freie Radikale zu fangen und dadurch die durch oxidativen Stress verursachten DNA-Schäden zu hemmen und die antioxidative Kapazität zu erhöhen.
Das ätherische Öl von Elsholtzia hat eine gewisse hemmende Wirkung auf empfindliche und arzneimittelresistente Bakterien und hat eine starke hemmende Wirkung auf Pseudomonas aeruginosa, Shigella dysentery, Candida albicans und Aspergillus flavus. Forscher haben herausgefunden, dass das ätherische Öl von Elsholtzia eine starke antibakterielle Wirkung auf Pseudomonas aeruginosa, Escherichia coli und Methicillin-resistenten Staphylococcus aureus hat, was mit unseren Forschungsergebnissen übereinstimmt. Die Forschung hat gezeigt, dass Thymol die Biofilmsynthese von Methicillin-resistentem Staphylococcus aureus reduzieren kann, indem es die Durchlässigkeit der bakteriellen Zellmembranen und das Elektrolyt-Ungleichgewicht stört und dadurch eine antibakterielle Wirkung erzielt. Dies könnte der Grund sein, warum das ätherische Öl von Elsholtzia starke antibakterielle Eigenschaften aufweist. Derzeit gibt es Berichte, die darauf hindeuten, dass ätherische Pflanzenöle die durch Pseudomonas aeruginosa verursachten Entzündungen bei Tieren hemmen können. In diesem Artikel verbesserte das ätherische Öl von Elsholtzia wirksam die durch eine Infektion mit Pseudomonas aeruginosa bei Mäusen verursachte Lungenentzündung und verhinderte bzw. verzögerte das Auftreten einer Lungenentzündung, die durch eine wiederholte Infektion mit Levofloxacin-resistentem Pseudomonas aeruginosa verursacht wurde, was darauf hindeutet, dass das ätherische Öl von Elsholtzia das Potenzial hat, eine arzneimittelresistente Infektion mit Pseudomonas aeruginosa zu behandeln und eine Grundlage für die Entwicklung natürlicher Arzneimittelalternativen bei antibiotikaresistenten Infektionen zu bieten.
Zusammenfassend lässt sich sagen, dass das ätherische Öl von Elsholtzia eine gute antioxidative und hemmende Wirkung auf empfindliche und arzneimittelresistente Bakterien hat und gute Aussichten auf eine medizinische Anwendung bietet, die eine neue potenzielle Quelle für natürliche Antiinfektiva werden kann.